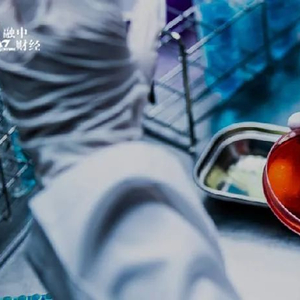

两年亏1亿美元。
本文4547字,约6.5分钟
作者 | 宋新澳 编辑 | 吾人
来源 | 融中财经
三位医学博士,在新加坡成立的miRNA技术公司,选择在香港IPO。
日前,Mirxes Holding Company Limited(以下简称“觅瑞”)向港交所递交上市申请。觅瑞起源于新加坡,由朱兴奋、周砺寒及邹瑞阳三位新加坡国立大学师生联合创立。
三位创始人都在生物技术相关领域有着长时间的积累。招股书介绍,朱兴奋在生物化学方面有超23年研究经验,曾任新加坡国立大学教授。周砺寒及邹瑞阳在生物技术行业(尤其是生物制药领域)有着十余年工作经验,并先后取得了新加坡国立大学的博士学位。三人里,邹瑞阳是中国国籍,其余两人均是新加坡籍,不过周砺寒曾在中国生活过一段时间,有资料显示,周砺寒生于贵州、长在浙江。
类似的研究背景,也促使三人走到了一起,2014年联手成立觅瑞。觅瑞主要开发及商业化基于血液的miRNA检测试剂盒,用于癌症及其他疾病筛查。IPO前,觅瑞已经完成D轮融资,股东不乏顶级投资机构,其中还能看到阿里巴巴18名创始人之一、原淘宝网总裁孙彤宇的身影。
一级市场对癌症筛查领域公司都有着类似的偏爱,比如美国癌症早筛公司Grail,在成立近5年后仍然亏损,却在同期完成了超数十亿美元的融资,早期投资人包括比尔盖茨、亚马逊Jeff Bezos等大佬。
又因为时代境遇的变化,企业拿到的钱最终去向各有不同。此前,核酸检测产品需求大增,觅瑞也加码其Fortitude™ COVID-19诊断试剂盒相关布局,但随着全球防疫形势变化,最终留下了“一地鸡毛”。觅瑞在5月提交的上市申请文件中称,“由于COVID-19疫情的影响自2022年以来有所减弱,预计传染病业务分部(尤其是Fortitude™销售)产生的收益于近期及中期将大幅减少。”
本次是觅瑞二次冲击港股IPO,上一次是在2023年7月,彼时公布的文件披露了这家公司紧张的财务状况。其核心产品GASTROClear™的数据指标也受到外界质疑。此次赴港IPO,觅瑞财务状况有什么新变化?GASTROClear™“支棱”起来了吗?
01
百亿美元癌症筛查市场
觅瑞所在的癌症筛查市场规模广阔。据弗若斯特沙利文数据,在东南亚、中国、日本及美国等选定国家或地区,癌症筛查潜在市场(包括胃癌、肺癌、结直肠癌和肝癌筛查)2022年总规模约为456亿美元,并预计增至2032年的756亿美元,2022年至2032年的复合年增长率为5.2%。
早筛是癌症筛查行业的发展趋势,因为越早被发现,癌症的治愈率与生存率越高。WHO曾指出,全球40%的癌症是可以预防的。以肺癌为例,按照国际肺癌研究协会数据,最早期的肺癌患者5年生存期可高达92%,I期患者的5年生存率最差也在75%以上;而临床上最晚期的肺癌患者的5年生存率几乎为0。
癌症早筛包括传统检测和新型液体活检两种。传统的筛查方式主要有医学影像学检查、内镜检查等技术手段。液体活检中的“液体”包括血液、粪便、尿液、唾液以及其他体液样本,在这一方法上,“滴血验癌”有了实现的可能。兴业证券认为液体活检早筛在肝癌、结直肠癌和胰腺癌中最具发展前景,胃癌和食管癌中也具有一定的应用潜力,但检出率有待进一步提高。一些早筛公司也将“宝”压在了液体活检上。
觅瑞选择的就是液体活检赛道。其开发的基于血液的miRNA检测技术,源自公司创始人周砺寒的早期积累。招股书介绍,周砺寒早期成就包括共同开发新的miRNA qPCR检测平台,以及用于发现miRNA生物标志物及治疗靶点的集成型工作流。其亦是用于基因药物治疗的新试剂、用于胃癌诊断的miRNA生物标志物及用于早期乳腺癌诊断的血清miRNA生物标志物等新技术的发明者或共同发明者。
觅瑞首个切入的是胃癌早筛市场,核心产品是GASTROClear™。据介绍,GASTROClear™的检测仅需1毫升的血,和传统的胃镜检查手段相比更具简便性。据弗若斯特沙利文资料,觅瑞是全球为数不多的已获得分子癌症筛查行业*IVD产品监管批准的公司之一,同时也是全球范围内首家且唯一一家获得分子胃癌筛查IVD产品监管批准的公司。
尽管在胃癌早筛取得了先发优势,但随着癌症筛查行业技术变革、新产品层出不穷,觅瑞还需要不断开发新管线产品以保持竞争力。目前,觅瑞还有六种处于临床前阶段的候选产品,覆盖肝癌、结直肠癌、乳腺癌等疾病筛查。
02
10个月“烧光”5000万美元
癌症早筛理想化的“滴血验癌”有多受到关注?这是从硅谷到白宫,骗子与资本大佬都不想错过的机会。
2022年1月,硅谷血液检测初创公司Theranos创始人Elizabeth Holmes被判欺诈罪,原因是其提供的“滴血验癌”技术造假。而在这场骗局被发现前,该项目获得了甲骨文创始人拉里·埃里森、媒体大亨鲁伯特·默多克、沃尔玛的沃尔顿家族等投资。董事会中一度能看到美国前国务卿亨利·基辛格、乔治·舒尔茨等知名人物。
这一闹剧也反映了市场对“滴血验癌”的狂热。IPO前,觅瑞获得了包括复朴资本、华润正大生命科学基金、美国医疗基金Rock Springs Capital、EDBI、高榕资本等知名投资机构的投资。一众资本为觅瑞引入了重金,在招股书公布的B、C、D三轮融资中,觅瑞获得了约1.67亿美元融资。其中,D轮融资就发生在觅瑞首次递表的前脚,融资额度为5000万美元,获得这笔融资后,觅瑞的估值一跃至6亿美元。
拿钱快,觅瑞“烧钱”的速度也不慢。截至2024年4月22日,这三笔融资已经全部花完了。招股书显示,这些钱用在包括但不限于研发活动、公司业务的增长及扩张以及一般营运资金用途。
具体而言,对盈利产生影响的运营开支居高不下,销售及分销、研发、一般及行政开支三项一度超过同期收益总额。2022年-2023年,这三项支出合计5873.41万美元、7179.48万美元,占收益的比例分别为330.8%、296.9%。
类似企业的研发、销售支出都较高,因为在整个癌症早筛产业链中,上游仪器供应商和下游医院用户比较强势,所以行业竞争主要依托企业自身的研发能力,同时营销和渠道能力也不可或缺。
而在这三项支出中,觅瑞最高的是一般及行政开支。2022年-2023年,其一般及行政开支分别为2666.59万美元、3199.22万美元。觅瑞集团称,一般及行政开支的增加主要由于办公开支、折旧及摊销开支以及专业咨询费增加。融中财经观察,觅瑞一般及行政开支中,员工成本占比最高,2022年-2023年分别为42.7%、36.8%。在2023年,专业咨询费用大幅上涨,从2022年的751.11万美元增长至1044.14万美元。
远超同期收益的支出费用也令觅瑞的现金流也十分紧张。2022年-2023年,觅瑞经营现金流净额分别为-4803.48万美元、-4421.27万美元;投资现金流净额分别为-3043.21万美元、-423.81万美元。融资现金流净额,2023年转正为4477.43万美元,该项现金流来源主要依赖股东注资。
此外,觅瑞也坦白表示,2022年、2023年至2024年4月22日,其主要通过股权融资及债务融资为运营提供资金。并提到,随着业务的持续扩张及开发候选产品,可能须透过公开或私募股权发售、债务融资及其他来源获得更多资金。
在本次IPO前,觅瑞又拿到了新的钱。招股书显示,2024年4月,觅瑞取得来自外部贷款人融通2500万美元,及一名董事融通100万新加坡元、200万美元。其中,第三方贷款人提供的资金要求更高,招股书显示,该融通项下的任何贷款均按10%的年利率计息,利息按日累计。此贷款应于融通协议的日期起12个月内偿还,贷款人可酌情延长6个月。
这笔钱又能用多长时间呢?据觅瑞测算,假设未来平均现金消耗率为2023年的1.0倍,估计截至2024年2月29日的现金及现金等价物及收到来自独立第三方贷款人的贷款将能够维持其6.8个月财务稳定。
再着眼于本次IPO募资用途,同样对资金有着高要求,主要用于核心产品GASTROClear™的研发、监管备案、生产与商业化;为正在进行和计划进行的研发提供资金,以进一步开发管线产品;加强并整合“端到端”能力;用作营运资金及其他一般企业用途。
先不提扩大业务,对觅瑞而言,上市后,先拿到钱回一波“血”就十分重要。
03
谁来为亏损买单?
就像骗局被戳破,资本也不会一直为亏损买单。
市场已有所反应,曾经的明星癌症筛查企业不再风光。2023年,美股上市癌症筛查公司燃石医学不光未盈利,且营收出现同比下滑。截至2023年12月31日,燃石医学收入总额5.37亿元,同比减少4.6%;净亏损6.54亿元。投资者的态度体现在二级市场上,其股价从最高峰的近40美元/股一路下滑。
更早以前,在2023年10月,美股上市泛生子公告称,已正式签署私有化合并协议。泛生子提供业务包含癌症早筛等,2020年,该公司登陆纳斯达克,市值直冲15亿美元。但自2021年开始,其股价一路下跌。低迷的股价背后,是持续的亏损,2020年-2022年,泛生子归母净亏损分别为30.69亿元、4.96亿元及8.08亿元。
觅瑞同样尚未盈利,2022年-2023年觅瑞亏损持续扩大,年内亏损分别为5620.27万美元、6956.93万美元。
当热度散去,癌症筛查企业需要找到自己的“钱途”。癌症筛查提供商提供IVD产品及LDT服务。IVD是将产品直接销售给医院,医院直接检测。LDT是为医院、体检公司等机构提供检测服务,企业要想做大规模,需要覆盖更多的医院。
具体到一款产品能否成功商业化,受多方面因素影响。东吴证券指出,参考Exact Science结直肠癌筛查产品 Cologuard 2020年实现销售收入8.2亿美元,成为全球最成功商业化早筛产品,放量主要受益于优异产品性能(灵敏度92.3%,特异性86.6%)及对支付方(医保)、医生(临床指南、药企合作)和患者依从性(广告、远程诊疗)问题的解决。
再看觅瑞,有三款商业化产品GASTROClear™、LungClear™及Fortitude™。此前,觅瑞收入中有很大一部分来自新冠诊断试剂业务。随着COVID-19检测服务的需求下降,Fortitude™收入出现下滑,2022年-2023年,Fortitude™服务收益从408.14万美元下降至107.04万美元。同期,Fortitude™产品从340.73万美元增长至563.24万美元,但这也不过是吃老本。招股书显示,该部分收益增加主要是于2023年继续按照与若干客户预先商定的订单交付Fortitude™产品。
很明显,Fortitude™并不能在未来撑起觅瑞的收入来源。觅瑞也意识到这点,对此,其打算通过早期检测及精准多组学业务分部收益的增长(包括通过销售GASTROClear™)以抵消传染病业务分部收益的减少。
在最新的招股书中,这部分收入“支棱”起来了吗?
2022下半年,GASTROClear™在其他东南亚国家推出LDT服务;LungClear™也在东南亚和日本作为LDT服务商业化。这两部分对应的收益相应增长,2022年-2023年,GASTROClear™服务收益从62.23万美元增长至241.33万美元;LungClear™收益从121.16万美元增长至212.98万美元。
尽管商业化范围不断扩大,但GASTROClear™的产品性能受到了质疑。
诊断产品的“准确率”是综合指标,通过与金标准的比较,评判标准可分为检测灵敏度、特异性、PPV(阳性预测值)、NPV(阴性预测值) 等指标。
招股书显示,GASTROClear™对一期胃癌及对小于1厘米的早期病变的灵敏度分别为87.5%及75.0%,优于被视为金标准的胃镜针对一期胃癌的灵敏度(66%)。但GASTROClear™特异性为68.4%,低于胃镜的99.5%。特异性越低意味着假阳性的可能性越大,会导致患者接受更多不必要的后续检测,带来一定的身心和经济负担。
GASTROClear™在NPV的表现与胃镜一致均为99.5%。NPV越高,意味着受检者可以对阴性结果更加放心。而GASTROClear™的PPV为6.7%。PPV越低,意味着大量受检者会受到不必要的“惊吓”,并将持续地采取原本非必要的医疗行为,给患者造成经济和精神上的双重压力。但在PPV指标中,胃镜同样不高为6.2%。
但也不必对某一项指标的过低而产生焦虑,由于现有技术限制,不同定位的产品,追求的指标值有所不同。以结直肠癌为例,结直肠癌早筛对于敏感性的要求比特异性要高,因为“金标准”肠镜可以作为最后的确诊手段,但是要保证较高的敏感性才能避免漏掉阳性患者。
参考不少成功上市癌症筛查企业财务状况,都尚未盈利。但到了二级市场,还需要实打实的业绩赢得投资者的选择,二次冲击IPO,觅瑞能否如愿?